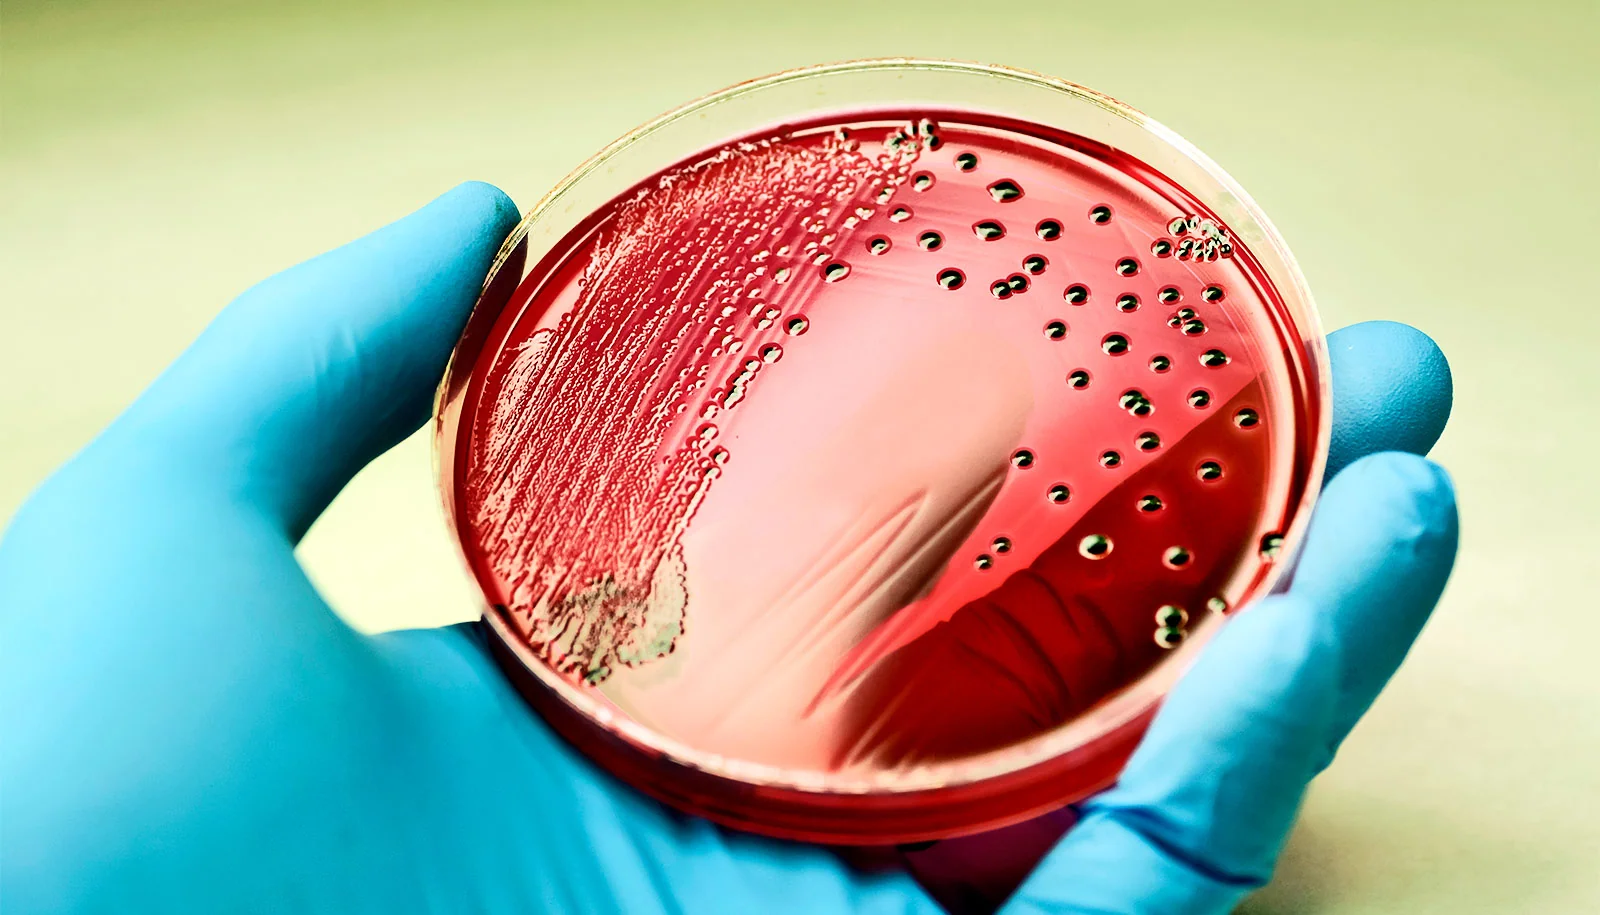

大灾后或有大疫!新西兰多地发布警告,这两种致病菌正处高发期!
后花园2023年2月24日援引1news网站报道:新西兰有关部门表示,在飓风Gabriell过后,沙门氏菌和钩端螺旋体病的感染率正在增加,为此,农民已被告知可通过给牲畜接种疫苗来帮助防疫。
新西兰肉品局Beef + Lamb NZ的生物安全和动物福利高级顾问Will Halliday表示,接触过受感染动物尿液的人感染疾病的风险最大。
他说,上述细菌还可能生活在被动物尿液污染的土壤和水中。
Halliday表示,此类疾病还可在挤奶、产犊、产羔、剪羊毛或屠宰和加工牲畜期间构成风险。
他说:“在飓风Gabriell之后,沙门氏菌和钩端螺旋体病已经在北岛东海岸地区呈上升趋势。”
前两天,奥克兰地区公共卫生服务部门就曾发布警告,表示钩端螺旋体病疑似爆发,而背后援引可能与最近的极端天气事件有关。
该部门表示,过去两周,已通报的感染病例呈上升趋势,并建议初级卫生保健机构考虑对生活在乡村或半乡村地区、有症状并与洪水或动物(包括老鼠)有过接触的患者进行检测。
Halliday表示,钩端螺旋体病菌主要生活在水中,洪水过后此类疾病往往会激增,而恶劣天气也可能会增加沙门氏菌的传播,后者则经常出现在生肉中。
他说,钩端螺旋体病可以感染所有的哺乳动物,它存在于被感染动物的肾脏和生殖道中。
Halliday提到:“所有哺乳动物都可能感染钩端螺旋体病,我们目前看到狗的感染病例正在增加。”
他说:“钩端螺旋体病可通过擦伤、皮肤伤口和粘膜进入人体,所以对农民来说,穿上防护服、盖住伤口、在接触动物后彻底清洗,保护自己不受动物尿液的伤害是很重要的。”
据Halliday介绍,农场里的积水或水坑可能是钩端螺旋体病的来源,其中包括水槽周围的水坑,动物可能在那里小便。
据悉,钩端螺旋体病的症状包括:头痛、流感样症状以及肌肉和肠道疼痛,但也可能以多种方式表现出来。
此外,在钩端螺旋体病抬头的同时,沙门氏菌感染病例也在上升。
Halliday表示,预防沙门氏菌和钩端螺旋体病的最好方式就是让农民给其牲畜接种疫苗,以防止人们感染致病,同时减少牲畜损失。
(责编:Gloria)